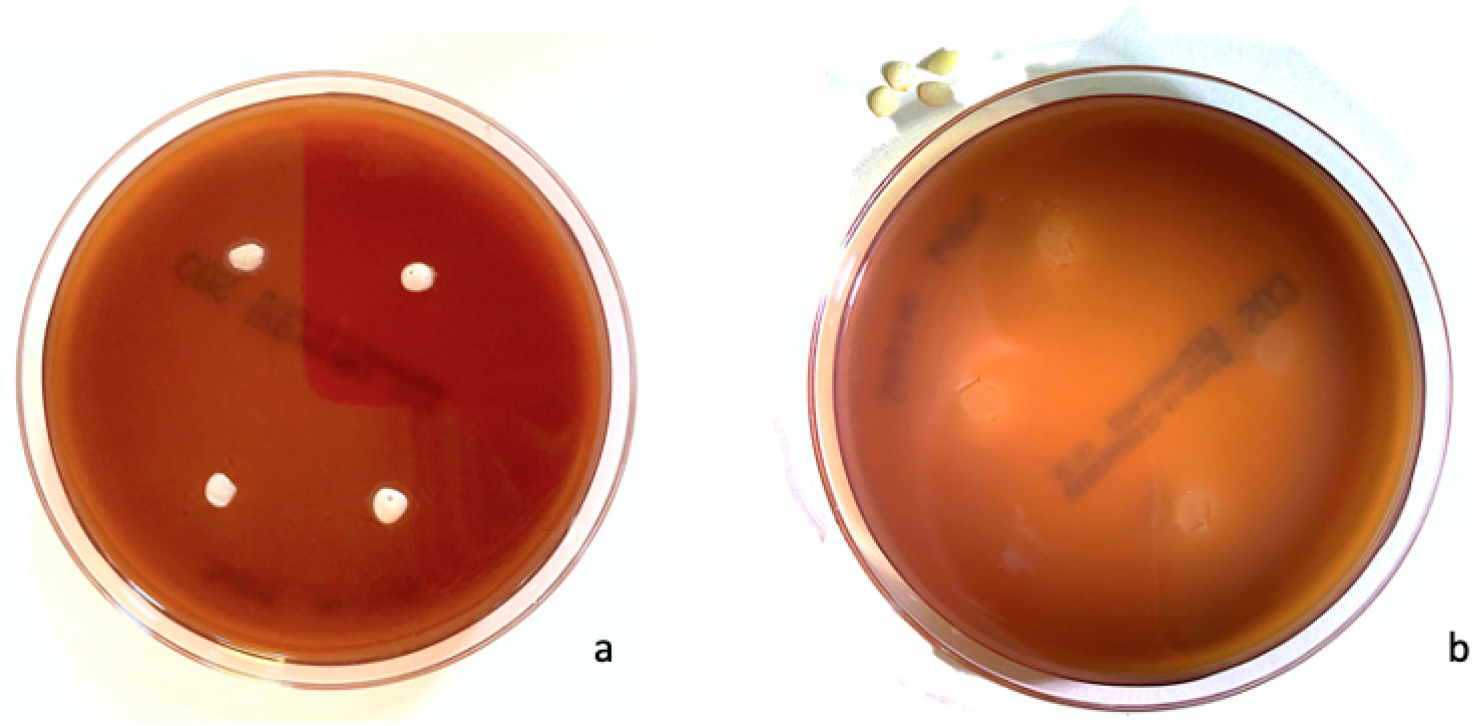
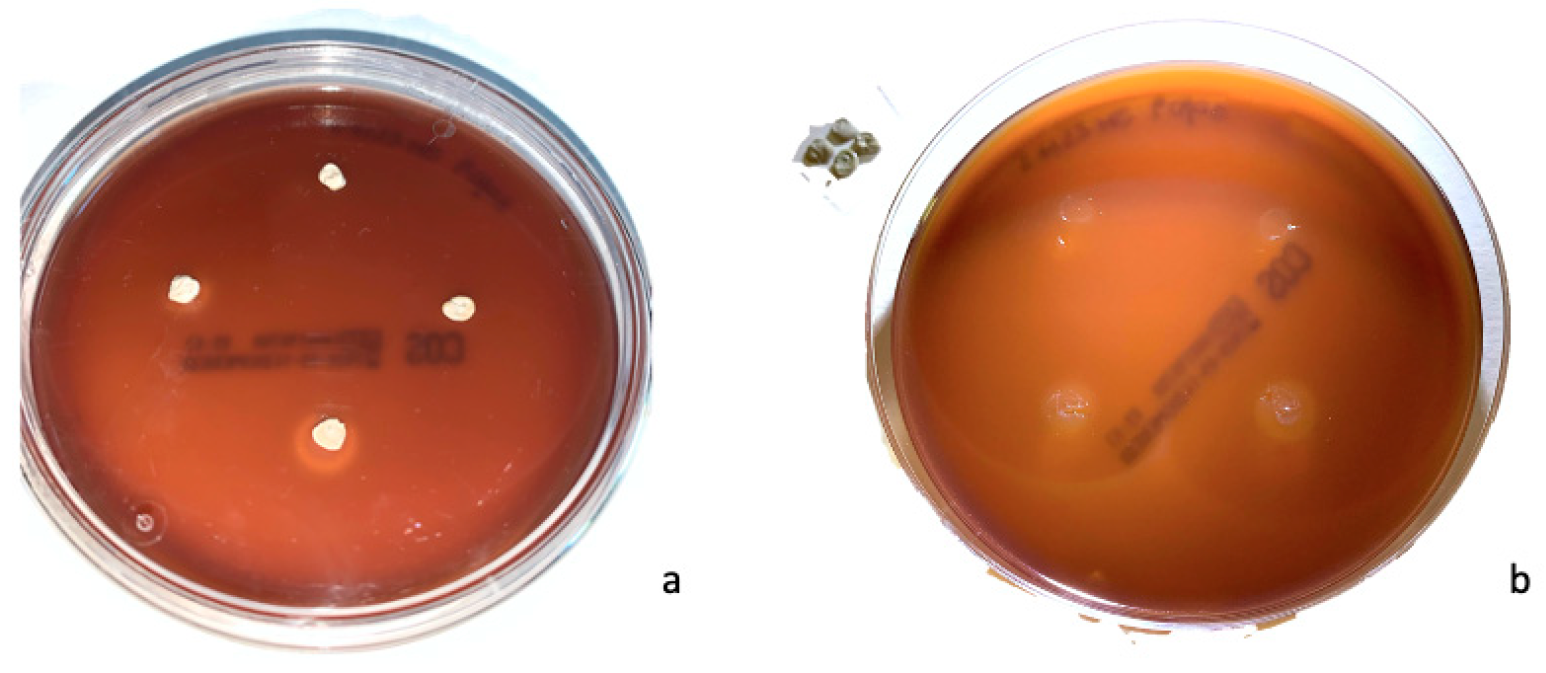

Evaluation of Antibacterial Activity of a Bioactive Restorative Material Versus a Glass-Ionomer Cement on Streptococcus Mutans: In-Vitro Study
Abstract
1. Introduction
2. Materials and Methods
3. Results
4. Discussion
5. Conclusions
Supplementary Materials
Author Contributions
Funding
Institutional Review Board Statement
Informed Consent Statement
Data Availability Statement
Acknowledgments
Conflicts of Interest
References
- Skeie, M.S.; Sen, A.; Dahllöf, G.; Fagerhaug, T.N.; Høvik, H.; Klock, K.S. Dental Caries at Enamel and Dentine Level among European Adolescents—A Systematic Review and Meta-Analysis. BMC Oral Health 2022, 22, 620. [Google Scholar] [CrossRef] [PubMed]
- Campus, G.; Cocco, F.; Strohmenger, L.; Cagetti, M.G. Caries Severity and Socioeconomic Inequalities in a Nationwide Setting: Data from the Italian National Pathfinder in 12-Years Children. Sci. Rep. 2020, 10, 15622. [Google Scholar] [CrossRef] [PubMed]
- Benelli, K.d.R.G.; Chaffee, B.W.; Kramer, P.F.; Knorst, J.K.; Ardenghi, T.M.; Feldens, C.A. Pattern of Caries Lesions and Oral Health-related Quality of Life throughout Early Childhood: A Birth Cohort Study. Eur. J. Oral Sci. 2022, 130, e12889. [Google Scholar] [CrossRef]
- Lara, J.S.; Romano, A.; Murisi, P.U.; Tedesco, T.K.; Mendes, F.M.; Soto-Rojas, A.E.; Alonso, C.; Campus, G. Impact of Early Childhood Caries Severity on Oral Health-related Quality of Life among Preschool Children in Mexico: A Cross-sectional Study. Int. J. Paediatr. Dent. 2022, 32, 334–343. [Google Scholar] [CrossRef] [PubMed]
- Zaror, C.; Matamala-Santander, A.; Ferrer, M.; Rivera-Mendoza, F.; Espinoza-Espinoza, G.; Martínez-Zapata, M.J. Impact of Early Childhood Caries on Oral Health-related Quality of Life: A Systematic Review and Meta-analysis. Int. J. Dent. Hyg. 2022, 20, 120–135. [Google Scholar] [CrossRef]
- Wong, H.M. Childhood Caries Management. Int. J. Environ. Res. Public Health 2022, 19, 8527. [Google Scholar] [CrossRef]
- Cagetti, M.G.; Carta, G.; Cocco, F.; Sale, S.; Congiu, G.; Mura, A.; Strohmenger, L.; Lingström, P.; Campus, G.; Italian Experimental Group on Oral Health; et al. Effect of Fluoridated Sealants on Adjacent Tooth Surfaces: A 30-Mo Randomized Clinical Trial. J. Dent. Res. 2014, 93, 59S–65S. [Google Scholar] [CrossRef]
- Veneri, F.; Bardellini, E.; Amadori, F.; Gobbi, E.; Belotti, R.; Majorana, A. Antibacterial Activity of New Hydrophilic Sealants: In Vitro Study. J. Indian Soc. Pedod. Prev. Dent. 2020, 38, 387–392. [Google Scholar] [CrossRef]
- Manchanda, S.; Sardana, D.; Liu, P.; Lee, G.H.; Li, K.Y.; Lo, E.C.; Yiu, C.K. Topical Fluoride to Prevent Early Childhood Caries: Systematic Review with Network Meta-Analysis. J. Dent. 2022, 116, 103885. [Google Scholar] [CrossRef]
- Ramamurthy, P.; Rath, A.; Sidhu, P.; Fernandes, B.; Nettem, S.; Fee, P.A.; Zaror, C.; Walsh, T. Sealants for Preventing Dental Caries in Primary Teeth. Cochrane Database Syst. Rev. 2022, 2, CD012981. [Google Scholar] [CrossRef]
- Wierichs, R.J.; Wolf, T.G.; Campus, G.; Carvalho, T.S. Efficacy of Nano-Hydroxyapatite on Caries Prevention—A Systematic Review and Meta-Analysis. Clin. Oral Investig. 2022, 26, 3373–3381. [Google Scholar] [CrossRef] [PubMed]
- Campus, G.; Carta, G.; Cagetti, M.G.; Bossù, M.; Sale, S.; Cocco, F.; Conti, G.; Nardone, M.; Sanna, G.; Strohmenger, L.; et al. Fluoride Concentration from Dental Sealants: A Randomized Clinical Trial. J. Dent. Res. 2013, 92, S23–S28. [Google Scholar] [CrossRef] [PubMed]
- Wolf, T.G.; Dekert, N.; Campus, G.; Ernst, C.-P. White-Opaque Flowable Composite Liner as a Depth Marker in Composite Restorations Prevents Tooth Substance Loss in Filling Removal: A Randomized Double-Blinded in Vitro Study. Clin. Oral Investig. 2022, 26, 2711–2717. [Google Scholar] [CrossRef] [PubMed]
- Zaffarano, L.; Salerno, C.; Campus, G.; Cirio, S.; Balian, A.; Karanxha, L.; Cagetti, M.G. Silver Diamine Fluoride (SDF) Efficacy in Arresting Cavitated Caries Lesions in Primary Molars: A Systematic Review and Metanalysis. Int. J. Environ. Res. Public Health 2022, 19, 12917. [Google Scholar] [CrossRef] [PubMed]
- Chisini, L.A.; Collares, K.; Cademartori, M.G.; de Oliveira, L.J.C.; Conde, M.C.M.; Demarco, F.F.; Corrêa, M.B. Restorations in Primary Teeth: A Systematic Review on Survival and Reasons for Failures. Int. J. Paediatr. Dent. 2018, 28, 123–139. [Google Scholar] [CrossRef] [PubMed]
- Askar, H.; Krois, J.; Göstemeyer, G.; Bottenberg, P.; Zero, D.; Banerjee, A.; Schwendicke, F. Secondary Caries: What Is It, and How It Can Be Controlled, Detected, and Managed? Clin. Oral Investig. 2020, 24, 1869–1876. [Google Scholar] [CrossRef]
- Askar, H.; Krois, J.; Göstemeyer, G.; Schwendicke, F. Secondary Caries Risk of Different Adhesive Strategies and Restorative Materials in Permanent Teeth: Systematic Review and Network Meta-Analysis. J. Dent. 2021, 104, 103541. [Google Scholar] [CrossRef]
- Sagmak, S.; Bahsi, E.; Ozcan, N.; Satici, O. Comparative Evaluation of Antimicrobial Efficacy and Fluoride Release of Seven Different Glass-Ionomer-Based Restorative Materials. Oral Health Prev. Dent. 2020, 18, 521–528. [Google Scholar] [CrossRef]
- Hill, R. Glass Ionomer Polyalkenoate Cements and Related Materials: Past, Present and Future. Br. Dent. J. 2022, 232, 653–657. [Google Scholar] [CrossRef]
- Wassel, M.; Allam, G. Anti-Bacterial Effect, Fluoride Release, and Compressive Strength of a Glass Ionomer Containing Silver and Titanium Nanoparticles. Indian J. Dent. Res. 2022, 33, 75. [Google Scholar] [CrossRef]
- Menezes-Silva, R.; Cabral, R.N.; Pascotto, R.C.; Borges, A.F.S.; Martins, C.C.; Navarro, M.F.d.L.; Sidhu, S.K.; Leal, S.C. Mechanical and Optical Properties of Conventional Restorative Glass-Ionomer Cements—A Systematic Review. J. Appl. Oral Sci. 2019, 27, e2018357. [Google Scholar] [CrossRef] [PubMed]
- Ching, H.S.; Luddin, N.; Kannan, T.P.; Ab Rahman, I.; Abdul Ghani, N.R.N. Modification of Glass Ionomer Cements on Their Physical-Mechanical and Antimicrobial Properties. J. Esthet. Restor. Dent. 2018, 30, 557–571. [Google Scholar] [CrossRef] [PubMed]
- May, E.; Donly, K.J. Fluoride Release and Re-Release from a Bioactive Restorative Material. Am. J. Dent. 2017, 30, 305–308. [Google Scholar] [PubMed]
- Lardani, L.; Derchi, G.; Marchio, V.; Carli, E. One-Year Clinical Performance of ActivaTM Bioactive-Restorative Composite in Primary Molars. Children 2022, 9, 433. [Google Scholar] [CrossRef]
- Melo, M.A.S.; Mokeem, L.; Sun, J. Bioactive Restorative Dental Materials—The New Frontier. Dent. Clin. N. Am. 2022, 66, 551–566. [Google Scholar] [CrossRef] [PubMed]
- Schmalz, G.; Hickel, R.; Price, R.B.; Platt, J.A. Bioactivity of Dental Restorative Materials: FDI Policy Statement. Int. Dent. J. 2023, 73, 21–27. [Google Scholar] [CrossRef]
- Vallittu, P.K.; Boccaccini, A.R.; Hupa, L.; Watts, D.C. Bioactive Dental Materials—Do They Exist and What Does Bioactivity Mean? Dent. Mater. 2018, 34, 693–694. [Google Scholar] [CrossRef]
- Mushashe, A.M.; de Almeida, S.A.; Ferracane, J.L.; Merritt, J.; Correr, G.M. Effect of Biofilm Exposure on Marginal Integrity of Composite Restorations. Am. J. Dent. 2020, 33, 201–205. [Google Scholar]
- Chan, D.C.; Chung, A.K.; Paranjpe, A. Antibacterial and Bioactive Dental Restorative Materials: Do They Really Work? Am. J. Dent. 2018, 31, 3B–5B. [Google Scholar]
- Khan, A.S.; Syed, M.R. A Review of Bioceramics-Based Dental Restorative Materials. Dent. Mater. J. 2019, 38, 163–176. [Google Scholar] [CrossRef]
- Malik, G.; Singh, A.; Sharma, D. Erratum Usage of the Term “Composite” for ActivaTM Bioactive Restorative Material. J. Conserv. Dent. 2022, 25, 680. [Google Scholar] [CrossRef] [PubMed]
- Shih, W.-Y. Microleakage in Different Primary Tooth Restorations. J. Chin. Med. Assoc. 2016, 79, 228–234. [Google Scholar] [CrossRef] [PubMed]
- Porter, G.C.; Tompkins, G.R.; Schwass, D.R.; Li, K.C.; Waddell, J.N.; Meledandri, C.J. Anti-Biofilm Activity of Silver Nanoparticle-Containing Glass Ionomer Cements. Dent. Mater. 2020, 36, 1096–1107. [Google Scholar] [CrossRef] [PubMed]
- Lima, F.G.; Romano, A.R.; Correa, M.B.; Demarco, F.F. Influence of Microleakage, Surface Roughness and Biofilm Control on Secondary Caries Formation around Composite Resin Restorations: An in Situ Evaluation. J. Appl. Oral Sci. 2009, 17, 61–65. [Google Scholar] [CrossRef] [PubMed]
- Busscher, H.J.; Rinastiti, M.; Siswomihardjo, W.; Van Der Mei, H.C. Biofilm Formation on Dental Restorative and Implant Materials. J. Dent. Res. 2010, 89, 657–665. [Google Scholar] [CrossRef] [PubMed]
- Schlafer, S.; Bornmann, T.; Paris, S.; Göstemeyer, G. The Impact of Glass Ionomer Cement and Composite Resin on Microscale PH in Cariogenic Biofilms and Demineralization of Dental Tissues. Dent. Mater. 2021, 37, 1576–1583. [Google Scholar] [CrossRef] [PubMed]
- Moshfeghi, H.; Haghgoo, R.; Sadeghi, R.; Niakan, M.; Rezvani, M. Antibacterial Activity of a Glass Ionomer Containing Silver Nanoparticles against Streptococcus Mutans and Streptococcus Sanguinis. Indian J. Dent. Res. 2020, 31, 589. [Google Scholar] [CrossRef]
- Lang, S.; Hao, J.; Mante, F.; Pavelic, K.; Ozer, F. The Effect of Zeolite Incorporation on the Physical Properties of Silver-Reinforced Glass Ionomer Cement. J. Mater. Sci. Mater. Med. 2022, 33, 38. [Google Scholar] [CrossRef]
- Sim, W.; Barnard, R.; Blaskovich, M.A.T.; Ziora, Z. Antimicrobial Silver in Medicinal and Consumer Applications: A Patent Review of the Past Decade (2007–2017). Antibiotics 2018, 7, 93. [Google Scholar] [CrossRef]
- Chen, J.; Zhao, Q.; Peng, J.; Yang, X.; Yu, D.; Zhao, W. Antibacterial and Mechanical Properties of Reduced Graphene-Silver Nanoparticle Nanocomposite Modified Glass Ionomer Cements. J. Dent. 2020, 96, 103332. [Google Scholar] [CrossRef]
- El-Wassefy, N.A.; El-Mahdy, R.H.; El-Kholany, N.R. The Impact of Silver Nanoparticles Integration on Biofilm Formation and Mechanical Properties of Glass Ionomer Cement. J. Esthet. Restor. Dent. 2018, 30, 146–152. [Google Scholar] [CrossRef] [PubMed]
- Xiao, J.; Grier, A.; Faustoferri, R.C.; Alzoubi, S.; Gill, A.L.; Feng, C.; Liu, Y.; Quivey, R.G.; Kopycka-Kedzierawski, D.T.; Koo, H.; et al. Association between Oral Candida and Bacteriome in Children with Severe ECC. J. Dent. Res. 2018, 97, 1468–1476. [Google Scholar] [CrossRef] [PubMed]
- Cai, J.-N.; Kim, D. Biofilm Ecology Associated with Dental Caries: Understanding of Microbial Interactions in Oral Communities Leads to Development of Therapeutic Strategies Targeting Cariogenic Biofilms. Adv. Appl. Microbiol. 2023, 122, 27–75. [Google Scholar] [CrossRef] [PubMed]
- Zayed, S.M.; Aboulwafa, M.M.; Hashem, A.M.; Saleh, S.E. Biofilm Formation by Streptococcus Mutans and Its Inhibition by Green Tea Extracts. AMB Express 2021, 11, 73. [Google Scholar] [CrossRef] [PubMed]
- Koo, H. Strategies to Enhance the Biological Effects of Fluoride on Dental Biofilms. Adv. Dent. Res. 2008, 20, 17–21. [Google Scholar] [CrossRef]
- Simmer, J.P.; Hardy, N.C.; Chinoy, A.F.; Bartlett, J.D.; Hu, J.C.-C. How Fluoride Protects Dental Enamel from Demineralization. J. Int. Soc. Prev. Community Dent. 2020, 10, 134–141. [Google Scholar] [CrossRef]
- Porenczuk, A.; Jankiewicz, B.; Naurecka, M.; Bartosewicz, B.; Sierakowski, B.; Gozdowski, D.; Kostecki, J.; Nasiłowska, B.; Mielczarek, A. A Comparison of the Remineralizing Potential of Dental Restorative Materials by Analyzing Their Fluoride Release Profiles. Adv. Clin. Exp. Med. 2019, 28, 815–823. [Google Scholar] [CrossRef]
- de Oliveira Roma, F.R.V.; de Oliveira, T.J.L.; Bauer, J.; Firoozmand, L.M. Resin-Modified Glass Ionomer Enriched with BIOGLASS: Ion-Release, Bioactivity and Antibacterial Effect. J. Biomed. Mater. Res. Part B Appl. Biomater. 2023, 111, 903–911. [Google Scholar] [CrossRef]
- Khere, C.H.; Hiremath, H.N.S.; Misar, P.; Gorie, N. Evaluation of Antibacterial Activity of Three Different Glass Ionomer Cements on Streptococcus Mutans: An in-Vitro Antimicrobial Study. Med. Pharm. Rep. 2019, 92, 288–293. [Google Scholar] [CrossRef]
- Kurt, A.; Tüzüner, T.; Baygın, Ö. Antibacterial Characteristics of Glass Ionomer Cements Containing Antibacterial Agents: An in Vitro Study. Eur. Arch. Paediatr. Dent. 2021, 22, 49–56. [Google Scholar] [CrossRef]
- Pires, C.W.; Pedrotti, D.; Lenzi, T.L.; Soares, F.Z.M.; Ziegelmann, P.K.; Rocha, R.d.O. Is There a Best Conventional Material for Restoring Posterior Primary Teeth? A Network Meta-Analysis. Braz. Oral Res. 2018, 32, e10. [Google Scholar] [CrossRef] [PubMed]
- Zhang, K.; Zhang, N.; Weir, M.D.; Reynolds, M.A.; Bai, Y.; Xu, H.H.K. Bioactive Dental Composites and Bonding Agents Having Remineralizing and Antibacterial Characteristics. Dent. Clin. N. Am. 2017, 61, 669–687. [Google Scholar] [CrossRef] [PubMed]
- Braga, R.R. Calcium Phosphates as Ion-Releasing Fillers in Restorative Resin-Based Materials. Dent. Mater. 2019, 35, 3–14. [Google Scholar] [CrossRef] [PubMed]
- Xu, H.H.K.; Weir, M.D.; Sun, L.; Moreau, J.L.; Takagi, S.; Chow, L.C.; Antonucci, J.M. Strong Nanocomposites with Ca, PO(4), and F Release for Caries Inhibition. J. Dent. Res. 2010, 89, 19–28. [Google Scholar] [CrossRef]
- Skrtic, D.; Antonucci, J.M.; Eanes, E.D.; Eichmiller, F.C.; Schumacher, G.E. Physicochemical Evaluation of Bioactive Polymeric Composites Based on Hybrid Amorphous Calcium Phosphates. J. Biomed. Mater. Res. 2000, 53, 381–391. [Google Scholar] [CrossRef]
- Okulus, Z.; Voelkel, A. Mechanical Properties of Experimental Composites with Different Calcium Phosphates Fillers. Mater. Sci. Eng. C 2017, 78, 1101–1108. [Google Scholar] [CrossRef]
- Huang, Q.; Liang, Z.; Li, J.; Bai, Y.; He, J.; Lin, Z. Size Dependence of Particulate Calcium Phosphate Fillers in Dental Resin Composites. ACS Omega 2021, 6, 35057–35066. [Google Scholar] [CrossRef]
- Moreau, J.L.; Sun, L.; Chow, L.C.; Xu, H.H.K. Mechanical and Acid Neutralizing Properties and Bacteria Inhibition of Amorphous Calcium Phosphate Dental Nanocomposite. J. Biomed. Mater. Res. Part B Appl. Biomater. 2011, 98, 80–88. [Google Scholar] [CrossRef]
- Xie, X.-J.; Xing, D.; Wang, L.; Zhou, H.; Weir, M.D.; Bai, Y.-X.; Xu, H.H. Novel Rechargeable Calcium Phosphate Nanoparticle-Containing Orthodontic Cement. Int. J. Oral Sci. 2017, 9, 24–32. [Google Scholar] [CrossRef]
- Chrószcz, M.W.; Barszczewska-Rybarek, I.M.; Kazek-Kęsik, A. Novel Antibacterial Copolymers Based on Quaternary Ammonium Urethane-Dimethacrylate Analogues and Triethylene Glycol Dimethacrylate. Int. J. Mol. Sci. 2022, 23, 4954. [Google Scholar] [CrossRef]
- Featherstone, J.D.B. Dental Restorative Materials Containing Quaternary Ammonium Compounds Have Sustained Antibacterial Action. J. Am. Dent. Assoc. 2022, 153, 1114–1120. [Google Scholar] [CrossRef] [PubMed]
- De-la-Pinta, I.; Cobos, M.; Ibarretxe, J.; Montoya, E.; Eraso, E.; Guraya, T.; Quindós, G. Effect of Biomaterials Hydrophobicity and Roughness on Biofilm Development. J. Mater. Sci. Mater. Med. 2019, 30, 77. [Google Scholar] [CrossRef] [PubMed]
- Nakabayashi, N.; Iwasaki, Y. Copolymers of 2-Methacryloyloxyethyl Phosphorylcholine (MPC) as Biomaterials. Bio-Med. Mater. Eng. 2004, 14, 345–354. [Google Scholar]
- Zhang, N.; Ma, J.; Melo, M.A.S.; Weir, M.D.; Bai, Y.; Xu, H.H.K. Protein-Repellent and Antibacterial Dental Composite to Inhibit Biofilms and Caries. J. Dent. 2015, 43, 225–234. [Google Scholar] [CrossRef] [PubMed]
- Croll, T.P.; Berg, J.H.; Donly, K.J. Dental Repair Material: A Resin-Modified Glass-Ionomer Bioactive Ionic Resin-Based Composite. Compend. Contin. Educ. Dent. 2015, 36, 60–65. [Google Scholar]
- López-García, S.; Pecci-Lloret, M.P.; Pecci-Lloret, M.R.; Oñate-Sánchez, R.E.; García-Bernal, D.; Castelo-Baz, P.; Rodríguez-Lozano, F.J.; Guerrero-Gironés, J. In Vitro Evaluation of the Biological Effects of ACTIVA Kids BioACTIVE Restorative, Ionolux, and Riva Light Cure on Human Dental Pulp Stem Cells. Materials 2019, 12, 3694. [Google Scholar] [CrossRef]
- ElReash, A.A.; Hamama, H.; Eldars, W.; Lingwei, G.; Zaen El-Din, A.M.; Xiaoli, X. Antimicrobial Activity and PH Measurement of Calcium Silicate Cements versus New Bioactive Resin Composite Restorative Material. BMC Oral Health 2019, 19, 235. [Google Scholar] [CrossRef]
- Alrahlah, A. Diametral Tensile Strength, Flexural Strength, and Surface Microhardness of Bioactive Bulk Fill Restorative. J. Contemp. Dent. Pract. 2018, 19, 13–19. [Google Scholar] [CrossRef]
- Daabash, R.; Alshabib, A.; Alqahtani, M.Q.; Price, R.B.; Silikas, N.; Alshaafi, M.M. Ion Releasing Direct Restorative Materials: Key Mechanical Properties and Wear. Dent. Mater. 2022, 38, 1866–1877. [Google Scholar] [CrossRef]
- Ong, J.; Yap, A.; Abdul Aziz, A.; Yahya, N. Flexural Properties of Contemporary Bioactive Restorative Materials: Effect of Environmental PH. Oper. Dent. 2023, 48, 90–97. [Google Scholar] [CrossRef]
- Wuersching, S.N.; Högg, C.; Kohl, L.; Reichl, F.-X.; Hickel, R.; Kollmuss, M. Leaching Components and Initial Biocompatibility of Novel Bioactive Restorative Materials. Dent. Mater. 2023, 39, 293–304. [Google Scholar] [CrossRef]
- Chandrasekhar, S.N.; Mallikarjun, S.B.; Salim, H.P. Comparative Evaluation of Antibacterial Activity of Probiotics SK12 and SM18: An In Vitro Study. Int. J. Clin. Pediatr. Dent. 2020, 13, 611–616. [Google Scholar] [CrossRef] [PubMed]
- Han, S.Y.; Roh, J.; Jung, Y.S.; Kim, K.R. Evaluation of antimicrobial activity of chlorhexidine-containing oral gels against aspiration pneumonia-inducing bacteria: An In Vitro study. Indian J. Dent. Res. 2022, 33, 90–93. [Google Scholar] [CrossRef] [PubMed]
- Lila-Krasniqi, Z.D.; Bajrami Halili, R.; Hamza, V.; Krasniqi, S. Evaluation of Antimicrobial Effectiveness of Dental Cement Materials on Growth of Different Bacterial Strains. Med. Sci. Monit. Basic Res. 2022, 28, e937893. [Google Scholar] [CrossRef] [PubMed]

| Material | Min [mm] | Max [mm] | Mean | SD | p a | |
|---|---|---|---|---|---|---|
| ACTIVA™ | 6.0 | 12.5 | 8.1 | 1.0 | <0.0001 * | 0.83 |
| Ketac™ Silver | 6.0 | 13.0 | 8.5 | 1.2 | 0.0002 * | |
Disclaimer/Publisher’s Note: The statements, opinions and data contained in all publications are solely those of the individual author(s) and contributor(s) and not of MDPI and/or the editor(s). MDPI and/or the editor(s) disclaim responsibility for any injury to people or property resulting from any ideas, methods, instructions or products referred to in the content. |
© 2023 by the authors. Licensee MDPI, Basel, Switzerland. This article is an open access article distributed under the terms and conditions of the Creative Commons Attribution (CC BY) license (https://creativecommons.org/licenses/by/4.0/).
Share and Cite
Conti, G.; Veneri, F.; Amadori, F.; Garzoni, A.; Majorana, A.; Bardellini, E. Evaluation of Antibacterial Activity of a Bioactive Restorative Material Versus a Glass-Ionomer Cement on Streptococcus Mutans: In-Vitro Study. Dent. J. 2023, 11, 149. https://doi.org/10.3390/dj11060149
Conti G, Veneri F, Amadori F, Garzoni A, Majorana A, Bardellini E. Evaluation of Antibacterial Activity of a Bioactive Restorative Material Versus a Glass-Ionomer Cement on Streptococcus Mutans: In-Vitro Study. Dentistry Journal. 2023; 11(6):149. https://doi.org/10.3390/dj11060149
Chicago/Turabian StyleConti, Giulio, Federica Veneri, Francesca Amadori, Alba Garzoni, Alessandra Majorana, and Elena Bardellini. 2023. "Evaluation of Antibacterial Activity of a Bioactive Restorative Material Versus a Glass-Ionomer Cement on Streptococcus Mutans: In-Vitro Study" Dentistry Journal 11, no. 6: 149. https://doi.org/10.3390/dj11060149
APA StyleConti, G., Veneri, F., Amadori, F., Garzoni, A., Majorana, A., & Bardellini, E. (2023). Evaluation of Antibacterial Activity of a Bioactive Restorative Material Versus a Glass-Ionomer Cement on Streptococcus Mutans: In-Vitro Study. Dentistry Journal, 11(6), 149. https://doi.org/10.3390/dj11060149

